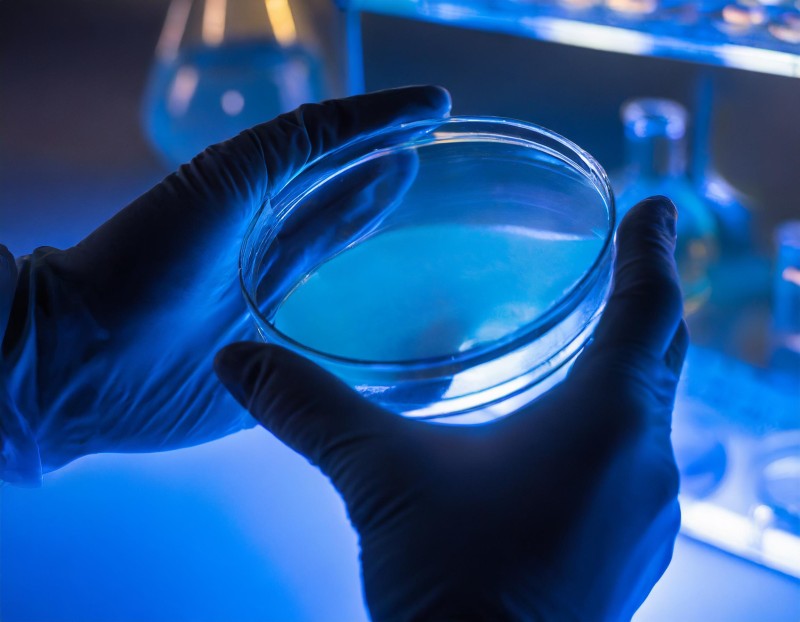
What Does Antimicrobial Mean?

Antimicrobial technology refers to the incorporation of specific active substances into materials to help inhibit the growth of microorganisms on treated products. In industrial and manufacturing applications, antimicrobial technologies are primarily used to support product protection by reducing microbial growth that can contribute to odor development, staining, and material degradation over time.
Silver ion technology is one example of an antimicrobial approach that can be integrated into materials such as plastics, textiles, coatings, and other surfaces during manufacturing. When incorporated into a treated article, silver ions interact with microorganisms at the surface level, helping limit their ability to grow on the product itself. This built-in functionality is designed to support long-term product performance and durability alongside routine cleaning and maintenance and is in no way meant to protect the user.